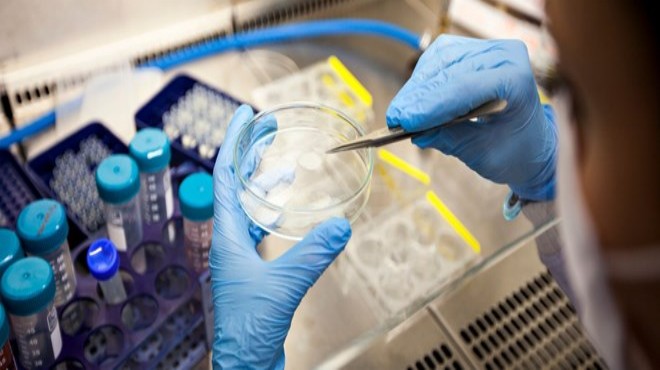

Yerel basında yer alan haberde, İsrail'deki Pluristem firmasının 3 ayrı sağlık merkezinde plasentadan aldığı kök hücreleri laboratuvar ortamında özel işlemlerden geçirdikten sonra ölüm riski yüksek 6 Covid-19 hastasına enjekte ettiği belirtildi.
Kök hücre araştırmalarıyla tanınan Pluristem'in uyguladığı bir haftalık tedavi sonucu böbrek veya solunum yetmezliği de bulunan hastaların tamamının Covid-19'u yenmeyi başardığı ifade edildi.
Uygulanan tedavi sayesinde 4 hastanın solunum değerlerinde de Covid-19'a yakalanmadan önceki döneme oranla iyileşme gözlendiği aktarıldı.
İsrail Sağlık Bakanlığı verilerine göre, ülkede Covid-19 nedeniyle hayatını kaybedenlerin sayısı 79'a, vaka sayısı ise 9 bin 755'e yükselirken, 864 kişi de iyileşti. (AA)
 |
 |
|||||
|
||||||
 Küfür, hakaret içeren; dil, din, ırk ayrımı yapan; yasalara aykırı ifade ve beyanda bulunan ve tamamı büyük harflerle yazılan yorumlar yayınlanmayacaktır. Neleri kabul ediyorum: IP adresimin kaydedileceğini, adli makamlarca istenmesi durumunda ip adresimin yetkililerle paylaşılacağını, yazılan yorumların sorumluluğunun tarafıma ait olduğunu, yazımın, yetkililerce, fikrim sorulmaksızın yayından kaldırılabileceğini bu siteye girdiğim andan itibaren kabul etmiş sayılırım. |













 Künye
Künye İletişim
İletişim Facebook
Facebook Twitter
Twitter RSS
RSS Sitene Ekle
Sitene Ekle Günün Haberleri
Günün Haberleri